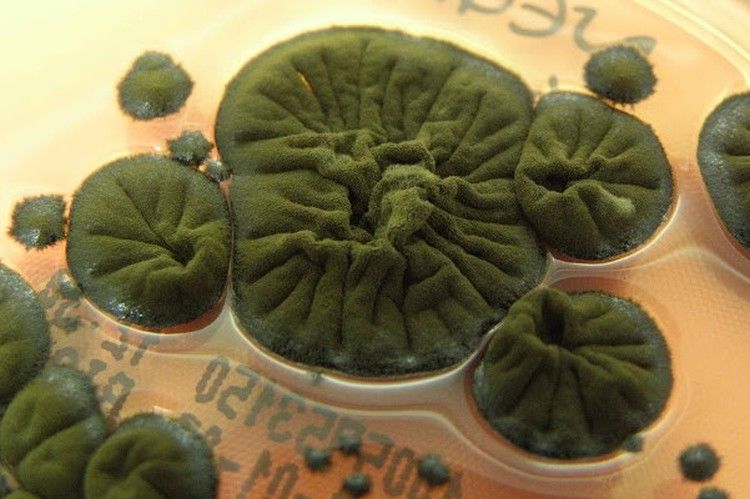
:  ,

На Чернобыльской АЭС, на стенах разрушенного энергоблока – в месте, зараженным радиацией сверх всякой меры, расплодились грибы. Ученые наблюдают за ними около 20 лет. Радиация грибам совсем не вредит. Наоборот, складывается впечатление, что Cladosporium sphaerospermum – такое у грибов название – радиацией питаются и за счет нее растут. То есть, в них идет не фотосинтез, как в других земных организмах, а так называемый радиосинтез, сообщает портал SienceAlert.
Под действием ионизирующего излучения Cladosporium sphaerospermum процветают и только чернеют, вырабатывая меланин - пигмент, который то ли защищает их, то ли способствует радиосинтезу.

Чернобыльская АЭС.
Александр КОЦ, Дмитрий СТЕШИН
Что конкретно происходит в чернобыльских грибах – до сих пор непонятно. Но подтверждения того, что эти удивительные создания потрясающим образом адаптировались и выработали механизм защиты от радиации, получены.
Грибы, собранные американскими и немецкими учеными, были доставлены на Международную Космическую Станцию (МКС). Их поместили в специальные лабораторные установки, одну выставили наружу – в космос под жесткое ионизирующее излучение, другую оставили внутри – под защитой корпуса станции. Грибы, находившиеся за бортом, росли лучше и быстрее, своих собратьев, оставшихся в более комфортных условия - почти в полтора раза. Более того, даже тонкий их слой (1,7 мм) ослаблял поступающую извне радиацию. Колония грибов будто бы поглощала её, создавая, по сути, биологический экран.
Черные плесневые чернобыльские грибки, процветающие в разрушенном блоке Чернобыльской АЭС. Им вообще не вредит радиация. Фото: Rui Tom?/Atlas of Mycology / atlasmicologia.blogspot.com.
Чернобыльские грибы воодушевляют авторов проектов, которые планируют буквально выращивать из них защитные оболочки – и для пилотируемых космических аппаратов, и для домов, в которых поселятся будущие колонисты на Луне и на Марсе. Предполагается, что дома будут расти сами из завезенных грибниц. Один из таких проектов под названием «Mycotecture Off Planet» уже финансирует американское космическое агентство в рамках программы перспективных разработок (NASA’s Innovative Advanced Concepts - NIAC).
- Мы поддерживаем прогрессивные идеи, какими бы странными они не казались, - примерно так выразился о «Mycotecture Off Planet» Джон Нельсон (John Nelson), руководитель программы NIAC. По его словам, на каркасах сооружений для работы в космосе и на других планетах будут выращивать толстые защитные грибные слои. Есть расчеты, что для Марса нужна грибная “изоляция” толщиной около 20 см,
Пока запланированные очередные эксперименты на МКС. Ученые, вырастив, конструкции из грибов, изучат, в самом ли деле они столь эффективны и прочны в космосе, как сейчас представляется.
Грибы из Чернобыля помогут первым колонистам выжить на Марсе
Грибы ориентируются в пространстве и шлют друг другу сообщения – нечто вроде SMS







































